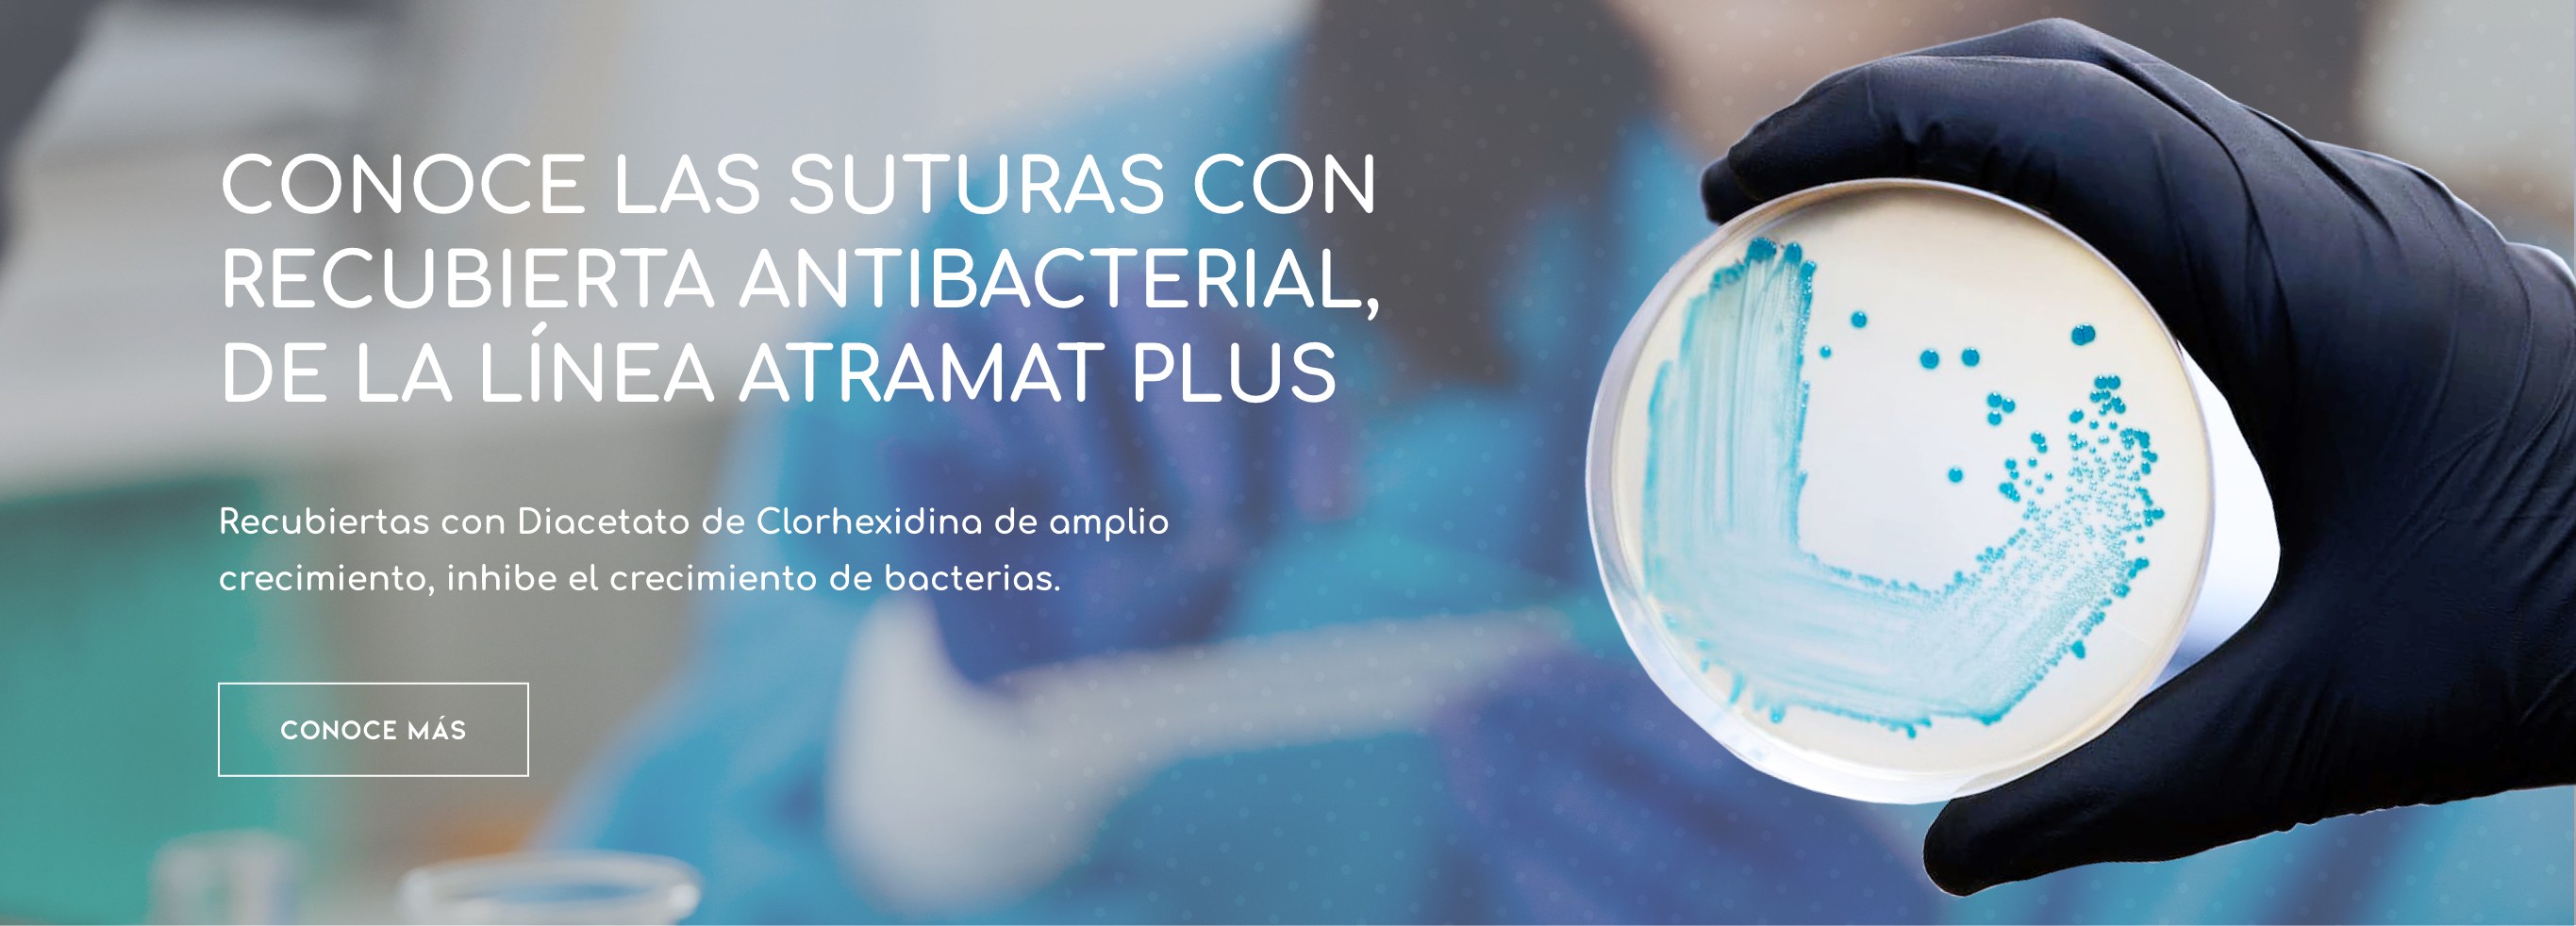
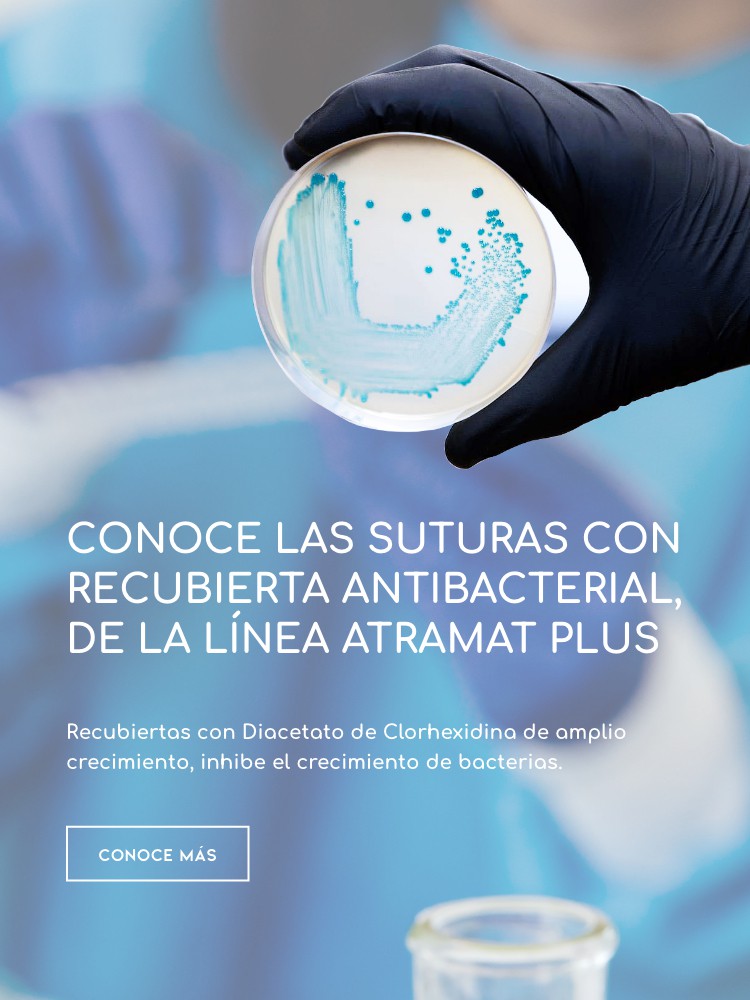

Los más vendidos
Conoce nuestros productos más solicitados
Categorías populares
Encuentra justo lo que estás buscando
Contamos con un amplio catálogo de productos y suturas Premium.
Realizamos envíos a todo México.
Somos orgullosamente distribuidores autorizados de la marca Atramat.
La satisfacción de nuestros clientes es nuestro principal objetivo.

.png)